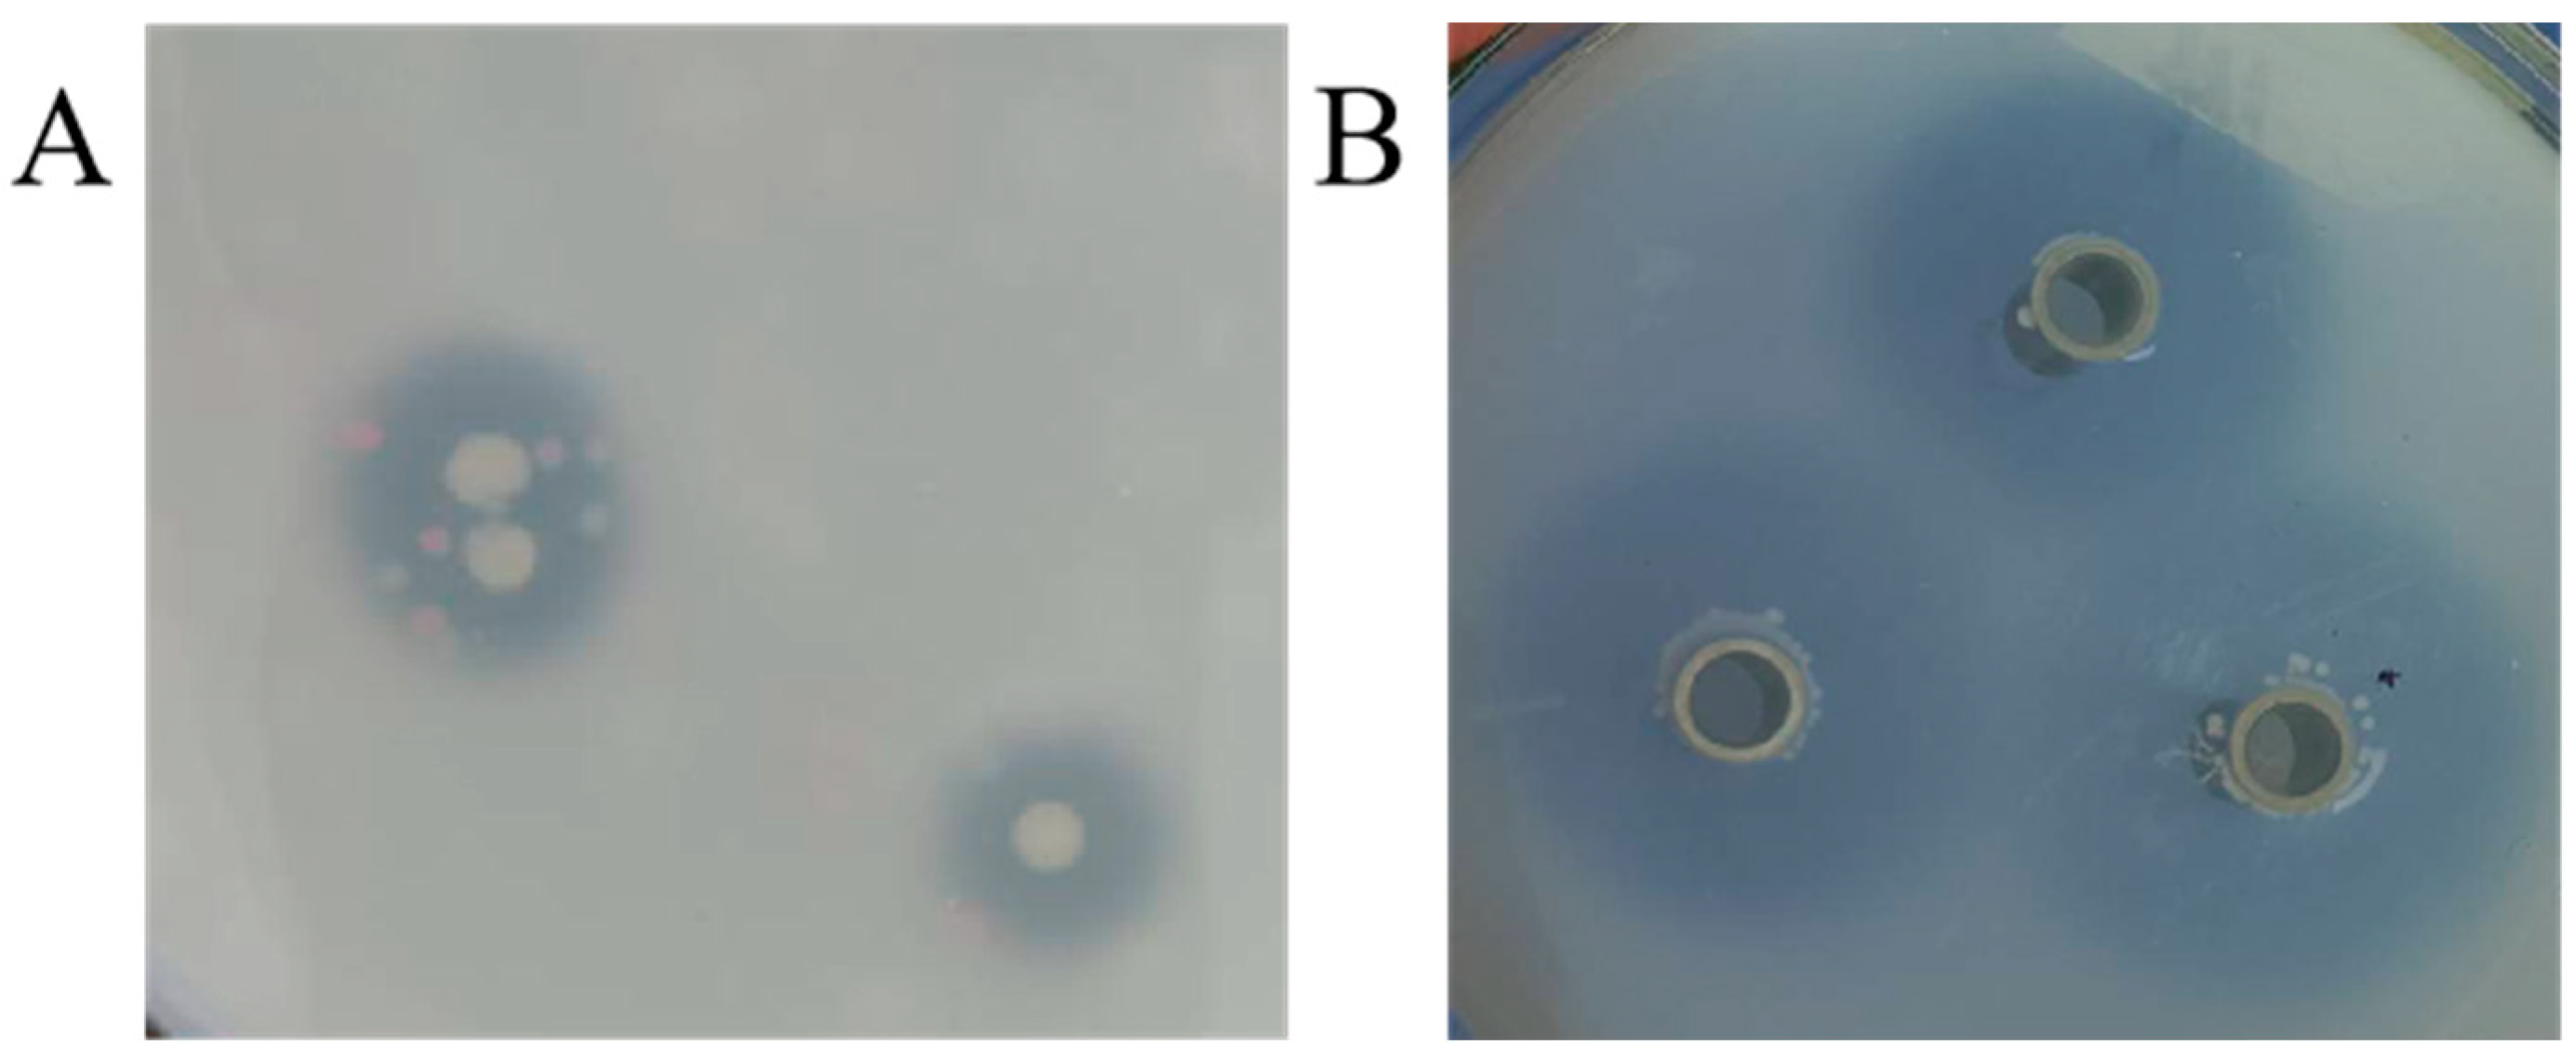
Microorganisms 11 00989 g001 Microorganisms 11 00989 g001

Characterization of Feruloyl Esterase from Klebsiella oxytoca Z28 and Its Application in the Release of Ferulic Acid from De-Starching Wheat Bran
Abstract
1. Introduction
2. Materials and Methods
2.1. Materials and Reagents
2.2. Culture Medium Conditions
2.3. Screening of FAE Producing Strains
2.4. Identification and Phylogenetic Tree Analysis of Ferulic Esterase Producing Strains
2.5. Construction and Induced Expression of Recombinant FAEplasmid
2.6. Effects of Temperature and pH on Activity and Stability of FAE
2.7. Effects of Metal Ions on FAE Activity
2.8. Release of Ferulic Acid from KoFAE Hydrolyzed De-Amylated Wheat Bran
3. Results and Discussion
3.1. Screening of Ferulic Esterase Producing Strains
3.2. Identification of Ferulic Esterase Producing Strain
3.3. Cloning and Expression of KoFae Gene
3.4. Influence of Temperature and pH on Activity and Stability of FAE
3.5. Effect of Metal Ions on KoFAE Activity
3.6. KoFAE Hydrolyzes de-Amylated Wheat Bran to Release FA
4. Conclusions
Supplementary Materials
Author Contributions
Funding
Data Availability Statement
Conflicts of Interest
References
- Oliveira, D.M.; Mota, T.R.; Oliva, B.; Segato, F.; Marchiosi, R.; Ferrarese-Filho, O.; Faulds, C.B.; dos Santos, W.D. Feruloyl esterases: Biocatalysts to overcome biomass recalcitrance and for the production of bioactive compounds. Bioresour. Technol. 2019, 278, 408–423. [Google Scholar] [CrossRef] [PubMed]
- Benoit, I.; Navarro, D.; Marnet, N.; Rakotomanomana, N.; Lesage-Meessen, L.; Sigoillot, J.-C.; Asther, M.; Asther, M. Feruloyl esterases as a tool for the release of phenolic compounds from agro-industrial by-products. Carbohydr. Res. 2006, 341, 1820–1827. [Google Scholar] [CrossRef]
- Faulds, C.B. What can feruloyl esterases do for us? Phytochem. Rev. 2010, 9, 121–132. [Google Scholar] [CrossRef]
- Lynch, J.P.; Prema, D.; Hamme, J.D.V.; Church, J.S.; Beauchemin, K.A. Fiber degradability, chemical composition and conservation characteristics of alfalfa haylage ensiled with exogenous fibrolytic enzymes and a ferulic acid esterase-producing inoculant. Can. J. Anim. Sci. 2014, 94, 697–704. [Google Scholar] [CrossRef]
- Record, E.; Asther, M.; Sigoillot, C.; Pagès, S.; Punt, P.J.; Delattre, M.; Haon, M.; van den Hondel, C.A.M.J.J.; Sigoillot, J.C.; Lesage-Meessen, L.; et al. Overproduction of the Aspergillus niger feruloyl esterase for pulp bleaching application. Appl. Microbiol. Biotechnol. 2003, 62, 349–355. [Google Scholar] [CrossRef]
- Dilokpimol, A.; Mäkelä, M.R.; Aguilar-Pontes, M.V.; Benoit-Gelber, I.; Hildén, K.S.; de Vries, R.P. Diversity of fungal feruloyl esterases: Updated phylogenetic classification, properties, and industrial applications. Biotechnol. Biofuels 2016, 9, 231. [Google Scholar] [CrossRef]
- Leonard, W.; Zhang, P.; Ying, D.; Fang, Z. Hydroxycinnamic acids on gut microbiota and health. Compr. Rev. Food Sci. Food Saf. 2021, 20, 710–737. [Google Scholar] [CrossRef]
- Song, Y.; Wu, M.-S.; Tao, G.; Lu, M.-W.; Lin, J.; Huang, J.-Q. Feruloylated oligosaccharides and ferulic acid alter gut microbiome to alleviate diabetic syndrome. Food Res. Int. 2020, 137, 109410. [Google Scholar] [CrossRef]
- Fu, Z.; Zhu, Y.; Teng, C.; Fan, G.; Li, X. Biochemical characterization of a novel feruloyl esterase from Burkholderia pyrrocinia B1213 and its application for hydrolyzing wheat bran. 3 Biotech 2021, 12, 24. [Google Scholar] [CrossRef]
- Gopalan, N.; Nampoothiri, K.M.; Szakacs, G.; Parameswaran, B.; Pandey, A. Solid-state fermentation for the production of biomass valorizing feruloyl esterase. Biocatal. Agric. Biotechnol. 2016, 7, 7–13. [Google Scholar] [CrossRef]
- Suzuki, K.; Hori, A.; Kawamoto, K.; Thangudu, R.R.; Ishida, T.; Igarashi, K.; Samejima, M.; Yamada, C.; Arakawa, T.; Wakagi, T.; et al. Crystal structure of a feruloyl esterase belonging to the tannase family: A disulfide bond near a catalytic triad. Proteins Struct. Funct. Bioinform. 2014, 82, 2857–2867. [Google Scholar] [CrossRef]
- Pérez-Rodríguez, N.; Outeiriño, D.; Torrado Agrasar, A.; Domínguez, J.M. Vine Trimming Shoots as Substrate for Ferulic Acid Esterases Production. Appl. Biochem. Biotechnol. 2017, 181, 813–826. [Google Scholar] [CrossRef]
- Rina, S.; Kuikui, N.; Tianwei, W.; Xiaopan, Y.; Jie, Z.; Yayong, L.; Weixiong, S.; Liu, Y.; Chen, J.; Jin, Z. Effects of ferulic acid esterase-producing Lactobacillus fermentum and cellulase additives on the fermentation quality and microbial community of alfalfa silage. PeerJ 2019, 7, e7712. [Google Scholar]
- Xu, Z.; Wang, T.; Zhang, S. Extracellular secretion of feruloyl esterase derived from Lactobacillus crispatus in Escherichia coli and its application for ferulic acid production. Bioresour. Technol. 2019, 288, 121526. [Google Scholar] [CrossRef]
- Xiaoli, D.; Yiwei, D.; Tao, Z. Characterization of Feruloyl Esterase from Bacillus pumilus SK52.001 and Its Application in Ferulic Acid Production from De-Starched Wheat Bran. Foods 2021, 10, 1229. [Google Scholar]
- Mandelli, F.; Brenelli, L.B.; Almeida, R.F.; Goldbeck, R.; Wolf, L.D.; Hoffmam, Z.B.; Ruller, R.; Rocha, G.J.M.; Mercadante, A.Z.; Squina, F.M. Simultaneous production of xylooligosaccharides and antioxidant compounds from sugarcane bagasse via enzymatic hydrolysis. Ind. Crops Prod. 2014, 52, 770–775. [Google Scholar] [CrossRef]
- Wu, D.; Cai, G.; Li, X.; Li, B.; Lu, J. Cloning and expression of ferulic acid esterase gene and its effect on wort filterability. Biotechnol. Lett. 2018, 40, 711–717. [Google Scholar] [CrossRef]
- Goldstone, D.C.; Villas-Bôas, S.G.; Till, M.; Kelly, W.J.; Attwood, G.T.; Arcus, V.L. Structural and functional characterization of a promiscuous feruloyl esterase (Est1E) from the rumen bacterium Butyrivibrio proteoclasticus. Proteins: Struct. Funct. Bioinform. 2010, 78, 1457–1469. [Google Scholar] [CrossRef]
- Deng, H.; Jia, P.; Jiang, J.; Bai, Y.; Fan, T.-P.; Zheng, X.; Cai, Y. Expression and characterisation of feruloyl esterases from Lactobacillus fermentum JN248 and release of ferulic acid from wheat bran. Int. J. Biol. Macromol. 2019, 138, 272–277. [Google Scholar] [CrossRef]
- Atalah, J.; Cáceres-Moreno, P.; Espina, G.; Blamey, J.M. Thermophiles and the applications of their enzymes as new biocatalysts. Bioresour. Technol. 2019, 280, 478–488. [Google Scholar] [CrossRef]
- Wefers, D.; Cavalcante, J.J.V.; Schendel, R.R.; Deveryshetty, J.; Wang, K.; Wawrzak, Z.; Mackie, R.I.; Koropatkin, N.M.; Cann, I. Biochemical and Structural Analyses of Two Cryptic Esterases in Bacteroides intestinalis and their Synergistic Activities with Cognate Xylanases. J. Mol. Biol. 2017, 429, 2509–2527. [Google Scholar] [CrossRef] [PubMed]
- Gao, L.; Wang, M.; Chen, S.; Zhang, D. Biochemical characterization of a novel feruloyl esterase from Penicillium piceum and its application in biomass bioconversion. J. Mol. Catal. B Enzym. 2016, 133, S388–S394. [Google Scholar] [CrossRef]
- Wang, L.; Li, Z.; Zhu, M.; Meng, L.; Wang, H.; Ng, T.B. An acidic feruloyl esterase from the mushroom Lactarius hatsudake: A potential animal feed supplement. Int. J. Biol. Macromol. 2016, 93, 290–295. [Google Scholar] [CrossRef] [PubMed]
- Sang, S.L.; Li, G.; Hu, X.P.; Liu, Y.H. Molecular Cloning, Overexpression and Characterization of a Novel Feruloyl Esterase from a Soil Metagenomic Library. Microb. Physiol. 2011, 20, 196–203. [Google Scholar] [CrossRef]
- Zhang, R.; Lin, D.; Zhang, L.; Zhan, R.; Wang, S.; Wang, K. Molecular and Biochemical Analyses of a Novel Trifunctional Endoxylanase/Endoglucanase/Feruloyl Esterase from the Human Colonic Bacterium Bacteroides intestinalis DSM 17393. J. Agric. Food Chem. 2022, 70, 4044–4056. [Google Scholar] [CrossRef]
- Agrawal, D.; Tsang, A.; Chadha, B.S. Economizing the lignocellulosic hydrolysis process using heterologously expressed auxiliary enzymes feruloyl esterase D (CE1) and β-xylosidase (GH43) derived from thermophilic fungi Scytalidium thermophilum. Bioresour. Technol. 2021, 339, 125603. [Google Scholar] [CrossRef]
- Long, L.; Zhao, H.; Ding, D.; Xu, M.; Ding, S. Heterologous expression of two Aspergillus niger feruloyl esterases in Trichoderma reesei for the production of ferulic acid from wheat bran. Bioprocess Biosyst. Eng. 2018, 41, 593–601. [Google Scholar] [CrossRef]
- Liangkun, L.; Lianqiu, W.; Qunying, L.; Shaojun, D. Highly Efficient Extraction of Ferulic Acid from Cereal Brans by a New Type A Feruloyl Esterase from Eupenicillium parvum in Combination with Dilute Phosphoric Acid Pretreatment. Appl. Biochem. Biotechnol. 2020, 190, 1561–1578. [Google Scholar]

| Strain No. | Diameter of t Clear Circles (mm) | Strain No. | Diameter of Clear Circles (mm) |
|---|---|---|---|
| Z6 | 22.33 | 1-3 | 15.00 |
| Z28 | 22.87 | 2-1 | 0.00 |
| J1 | 2.00 | 2-2 | 21.00 |
| J2 | 0.00 | 2-3 | 2.67 |
| J3 | 2.83 | 2-4 | 21.00 |
| J4 | 0.67 | 3-1 | 14.00 |
| D1 | 8.33 | 3-2 | 17.00 |
| D2 | 6.07 | 3-3 | 19.00 |
| D3 | 8.97 | 4-1 | 16.67 |
| D4 | 12.83 | 4-2 | 15.33 |
| D5 | 17.00 | 4-3 | 11.33 |
| D8 | 7.67 | 5-1 | 7.00 |
| D9 | 18.33 | 5-2 | 14.00 |
| D6 | 21.33 | 5-3 | 22.67 |
| D7 | 17.00 | 5-4 | 19.67 |
| LC9 | 19.00 | 6-1 | 6.33 |
| JW1 | 18.00 | 6-2 | 11.00 |
| JW2 | 2.07 | ||
| 1-1 | 17.67 | ||
| 1-2 | 17.00 |
| Strain No. | FAE Activity (U/L) | Strain No. | FAE Activity (U/L) |
|---|---|---|---|
| D5 | 18.5 ± 0.5 | 1-2 | 23.4 ± 0.4 |
| D6 | 25.2 ± 0.3 | 2-2 | 7.7 ± 0.3 |
| D7 | 32.2 ± 0.5 | 2-4 | 3.1 ± 0.5 |
| D9 | 16.0 ± 0.5 | 3-1 | 13.7 ± 0.5 |
| Z6 | 18.7 ± 0.4 | 3-2 | 1.7 ± 0.1 |
| Z28 | 35.0 ± 0.6 | 3-3 | 34.0 ± 0.3 |
| J1 | 30.1 ± 0.6 | 4-2 | 7.9 ± 0.3 |
| JW1 | 29.0 ± 0.3 | 5-3 | 4.5 ± 0.4 |
| JW2 | 34.9 ± 0.1 | 5-4 | 14.9 ± 0.5 |
| LC9 | 17.9 ± 0.1 | 6-1 | 8.8 ± 0.3 |
| Metal Ions and Organic Compounds | Relative Activity/(%) |
|---|---|
| Co2+ | 78.17 ± 4.48 |
| Ba2+ | 58.22 ± 6.15 |
| Na+ | 105.95 ± 2.90 |
| Cu2+ | 50.86 ± 5.23 |
| Zn2+ | 81.14 ± 5.16 |
| Fe3+ | 79.05 ± 4.08 |
| Li+ | 72.85 ± 6.96 |
| Mn2+ | 60.33 ± 6.73 |
| Mg2+ | 79.42 ± 7.52 |
| Ca2+ | 55.56 ± 5.21 |
Disclaimer/Publisher’s Note: The statements, opinions and data contained in all publications are solely those of the individual author(s) and contributor(s) and not of MDPI and/or the editor(s). MDPI and/or the editor(s) disclaim responsibility for any injury to people or property resulting from any ideas, methods, instructions or products referred to in the content. |
© 2023 by the authors. Licensee MDPI, Basel, Switzerland. This article is an open access article distributed under the terms and conditions of the Creative Commons Attribution (CC BY) license (https://creativecommons.org/licenses/by/4.0/).
Share and Cite
Zhang, Y.; Feng, Z.; Xiang, H.; Zhang, X.; Yang, L. Characterization of Feruloyl Esterase from Klebsiella oxytoca Z28 and Its Application in the Release of Ferulic Acid from De-Starching Wheat Bran. Microorganisms 2023, 11, 989. https://doi.org/10.3390/microorganisms11040989
Zhang Y, Feng Z, Xiang H, Zhang X, Yang L. Characterization of Feruloyl Esterase from Klebsiella oxytoca Z28 and Its Application in the Release of Ferulic Acid from De-Starching Wheat Bran. Microorganisms. 2023; 11(4):989. https://doi.org/10.3390/microorganisms11040989
Chicago/Turabian StyleZhang, Yao, Zhiping Feng, Hongzhu Xiang, Xian Zhang, and Lijuan Yang. 2023. "Characterization of Feruloyl Esterase from Klebsiella oxytoca Z28 and Its Application in the Release of Ferulic Acid from De-Starching Wheat Bran" Microorganisms 11, no. 4: 989. https://doi.org/10.3390/microorganisms11040989
APA StyleZhang, Y., Feng, Z., Xiang, H., Zhang, X., & Yang, L. (2023). Characterization of Feruloyl Esterase from Klebsiella oxytoca Z28 and Its Application in the Release of Ferulic Acid from De-Starching Wheat Bran. Microorganisms, 11(4), 989. https://doi.org/10.3390/microorganisms11040989

